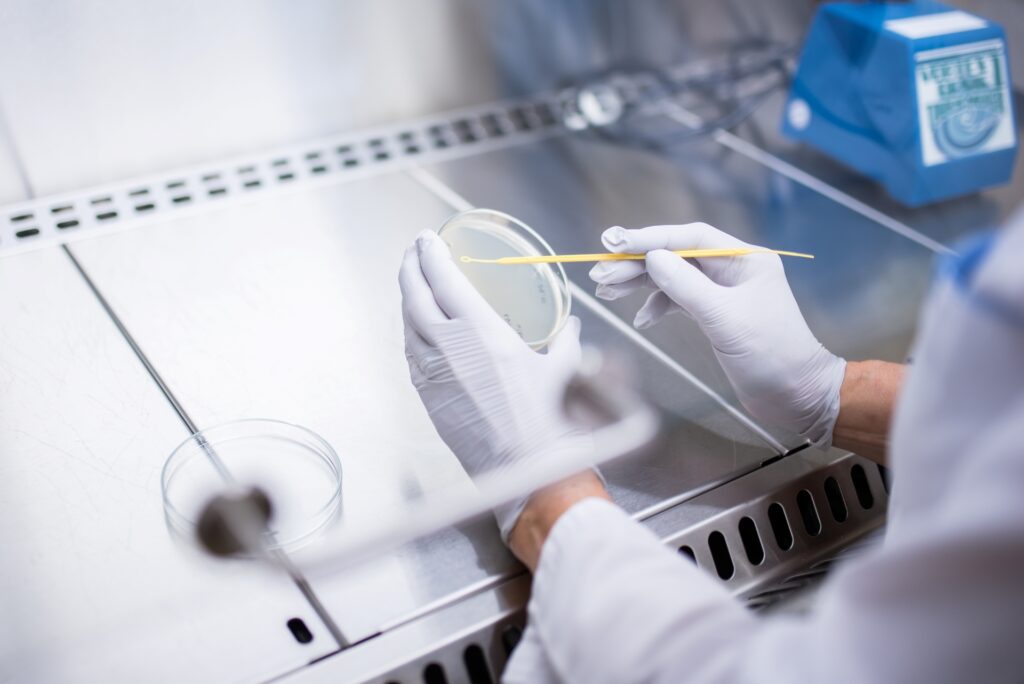

Badania jakości dostarczanej wody
Jesteśmy pewni jakości Wody Opolanki! Dział Laboratorium regularnie prowadzi w Opolu badania jakości wody dostarczanej do mieszkańców i odbiorców instytucjonalnych. Próbki pobierane są z ośmiu różnych punktów, uzgadnianych corocznie z Sanepidem, rozmieszczonych równomiernie na mapie sieci wodociągowej miasta. W ten sposób kontrolowane są porównywalne obszary, zgodnie z wymogami Sprawdź: Rozporządzenia Ministra Zdrowia w sprawie jakości wody przeznaczonej do spożycia przez ludzi.
Badania jakości wody prowadzone są w trybie ciągłym – dzięki czemu mamy pewność, że Woda Opolanka jest bezpieczna i możliwie najlepszej jakości. Aktualizowane wyniki udostępniane poniżej do pobrania i zapoznania, stanowią podsumowanie analiz z punktów zgodności na terenie sieci wodociągowej miasta Opola w danym miesiącu. Zobacz: Ocena jakości wody Powiatowego Inspektora Sanitarnego w Opolu (II kwartał 2024)
Aktualizowane wyniki badań jakości wody publikowane przez Dział Laboratorium Spółki WiK w Opolu:

Porównanie zawartości składników mineralnych Wody Opolanki z popularnymi wodami butelkowanymi oraz normami jakości wody:


